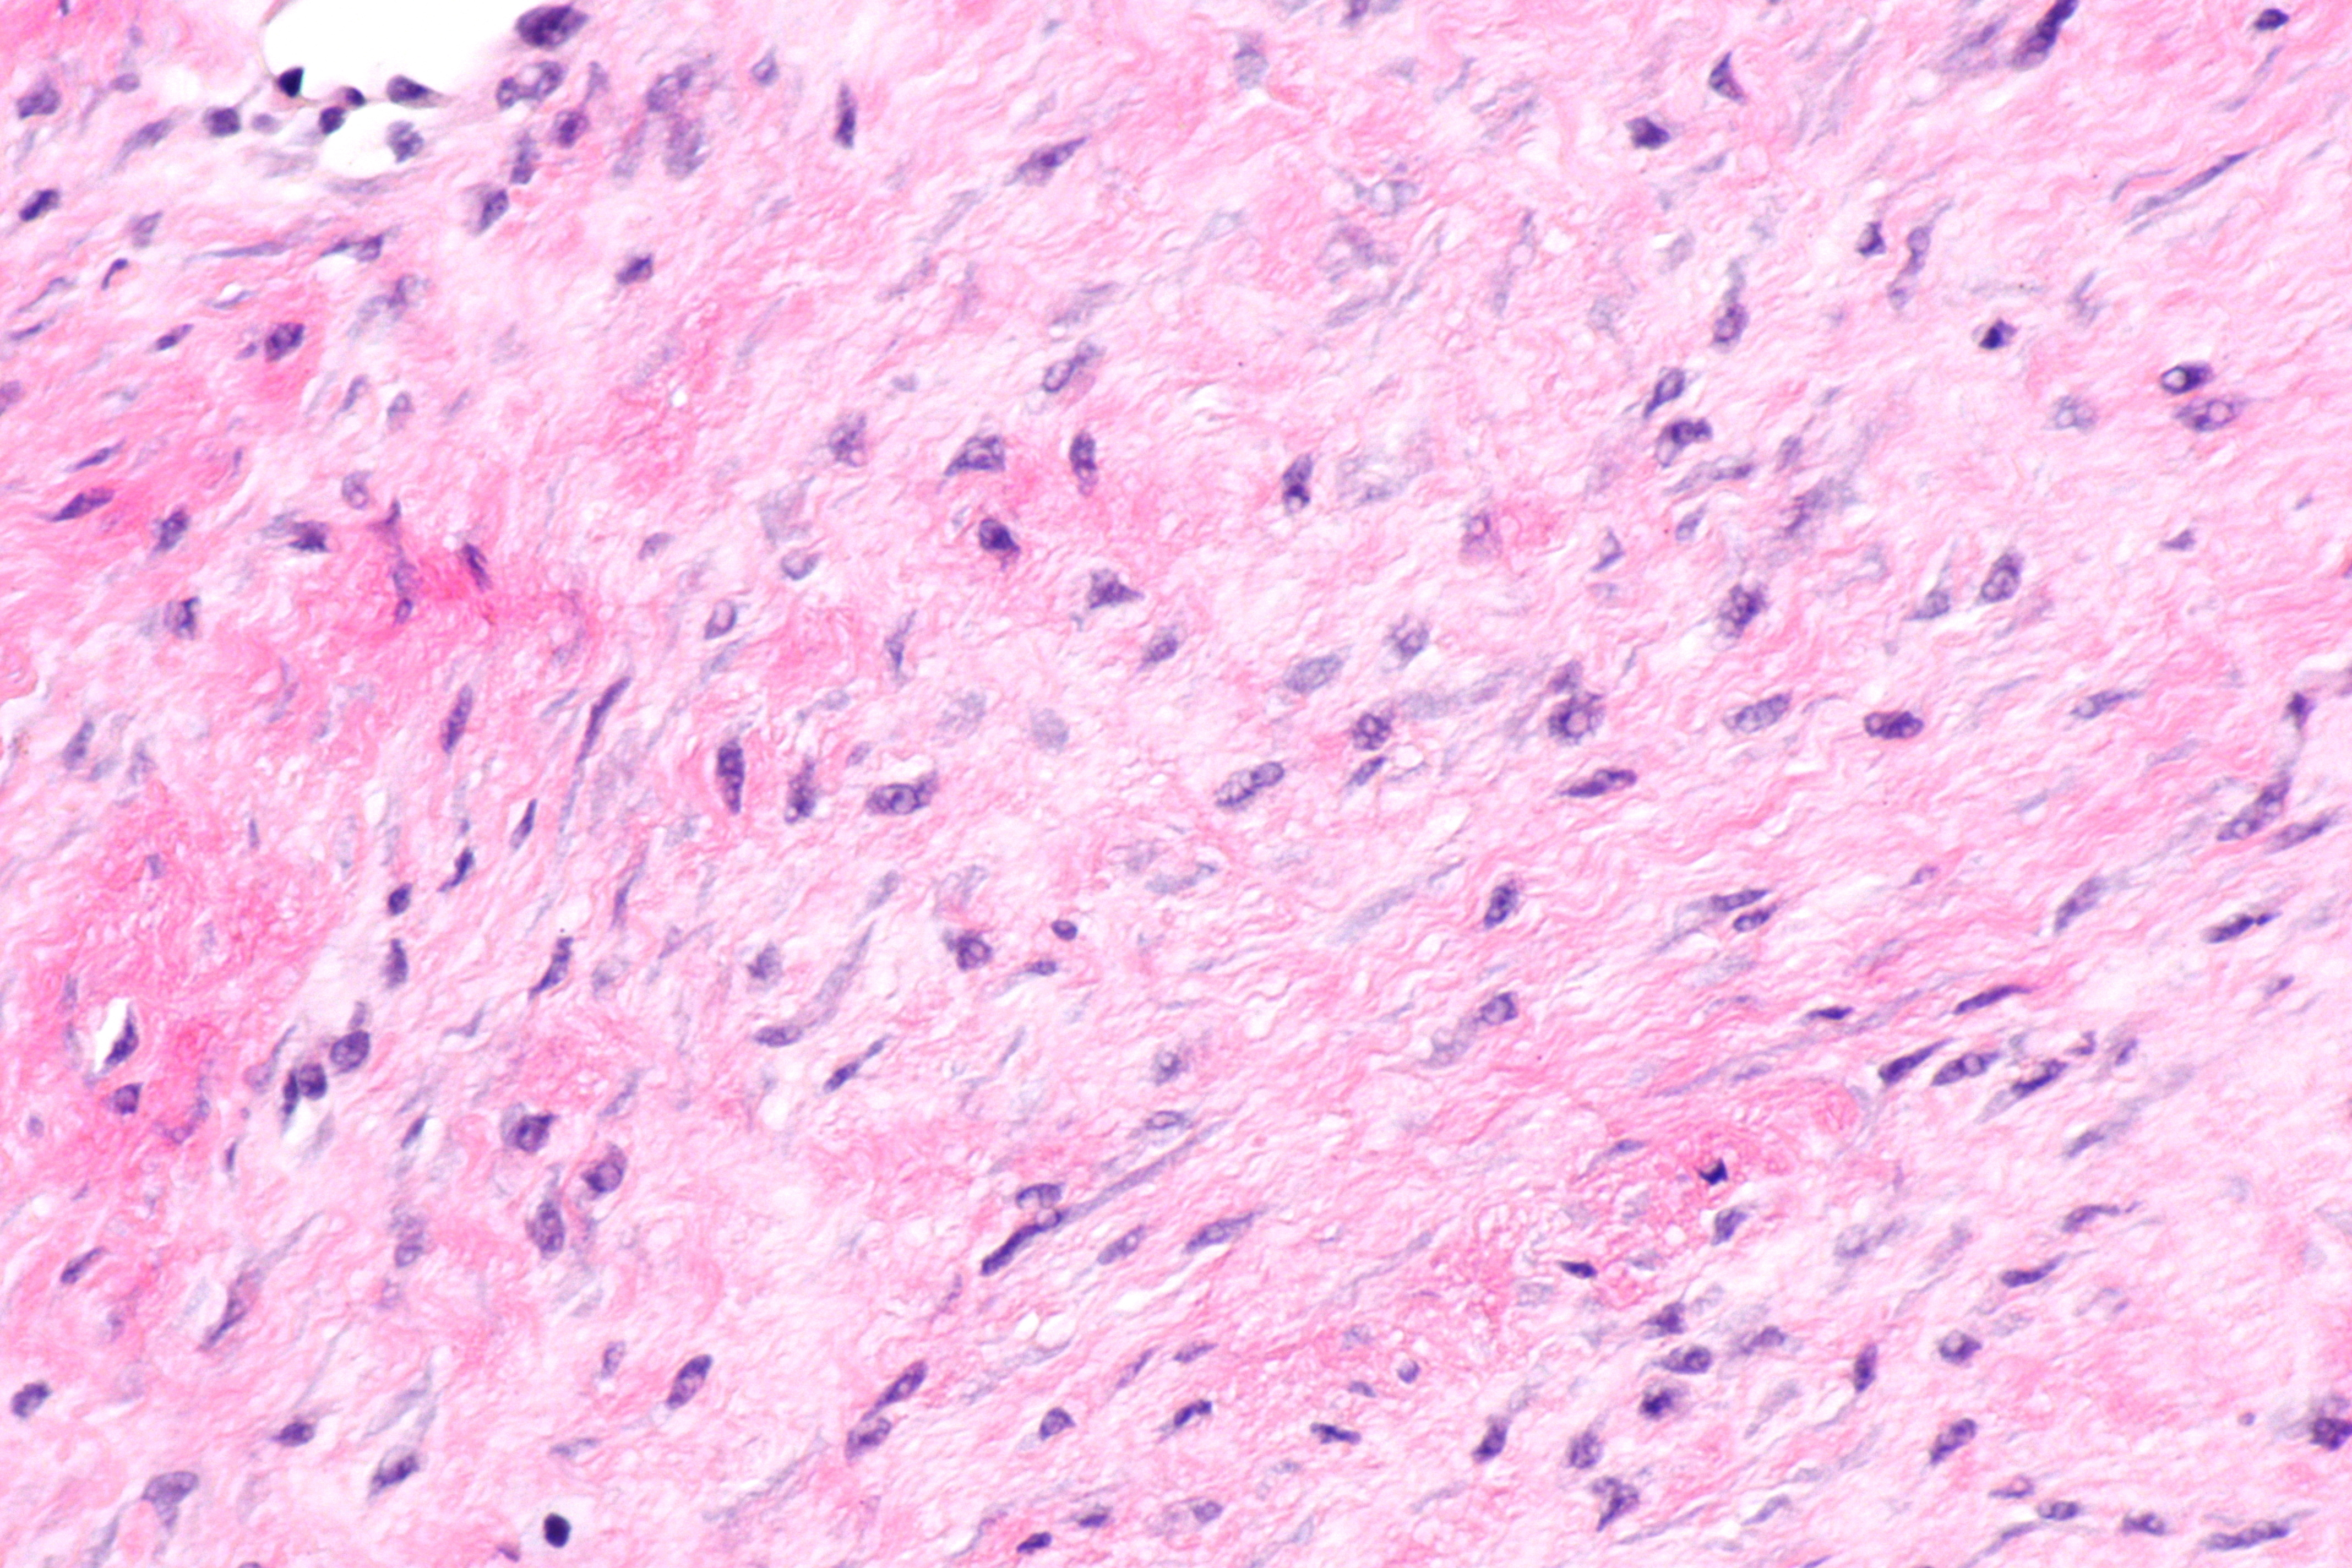
Histologic section of desmoid tumor tissue with spindle cells in fibrous connective tissue.

Desmoid tumors
By Sudha Thakor
Desmoid tumors, also known as aggressive fibromatosis, are rare fibroblastic neoplasms that present a significant therapeutic challenge.1 Although benign and non-metastasizing, these tumors can behave aggressively at the local level, infiltrating surrounding structures and causing morbidity.2,3 Their variable clinical course, ranging from indolent stability to persistent progression, requires nuanced, individualized management.2,3
Advances in molecular understanding and a growing emphasis on quality of life have reshaped treatment goals.4 Active surveillance is increasingly prioritized over surgery for certain tumor types, recognizing that intervention itself can carry lasting consequences.5
What are the symptoms of desmoid tumors?
Symptoms vary according to tumor location, size, and growth rate. Patients may present with a painless, palpable mass or experience pain, stiffness, or restricted movement because of local tissue infiltration.6 Intra-abdominal tumors may cause bowel obstruction or ischemia, while extra abdominal disease can lead to nerve compression or lymphatic obstruction, causing pain or tingling sensations.7
How are desmoid tumors diagnosed?
Following a physical exam, desmoids are diagnosed via imaging tests, such as a CT scan or MRI, to define tumor extent and assess involvement of surrounding structures. A core needle biopsy provides histologic confirmation.6
What are the treatments for desmoid tumors?
First-line active surveillance is preferred for patients with asymptomatic or minimally symptomatic disease.5,6 This strategy reflects evidence that desmoid tumors may remain stable or regress without treatment, avoiding unnecessary morbidity.5,6
For progressive or symptomatic disease, systemic therapy is central to management.6 Options include tyrosine kinase inhibitors and cytotoxic chemotherapy, with surgery or radiotherapy reserved for selected cases where potential benefits outweigh functional risk.6
Are desmoid tumors associated with genetic syndromes?
Yes. A subset of cases occur in patients with familial adenomatous polyposis because of germline APC mutations,8 with patients often presenting with intra‑abdominal disease and a more aggressive course.9
References
- Ibrahim, 2024. Desmoid-type fibromatosis: Current therapeutic strategies and future perspectives. https://www.doi.org/10.1016/j.ctrv.2023.102675
- Bektas, 2023. Desmoid tumors: A comprehensive review. https://www.doi.org/10.1007/s12325-023-02592-0
- Samip, 2024. Desmoid tumor. https://www.ncbi.nlm.nih.gov/books/NBK459231/
- Mangla, 2024. Desmoid tumors: Current perspective and treatment. https://www.doi.org/10.1007/s11864-024-01177-5
- Wagner, 2025. 5 facts about surgery for desmoid tumors. https://www.mydesmoidtumorteam.com/resources/facts-about-surgery-for-desmoid-tumors
- Cleveland Clinic, 2025. Desmoid tumors. https://my.clevelandclinic.org/health/diseases/22075-desmoid-tumors
- Venkat, 2010. Abdominal pain and colonic obstruction from an intra-abdominal desmoid tumor. https://pmc.ncbi.nlm.nih.gov/articles/PMC2978418/
- De Marchis, 2017. Desmoid tumors in familial adenomatous polyposis. https://pubmed.ncbi.nlm.nih.gov/28668823/
- Yang and Ding, 2023. Update on familial adenomatous polyposis-associated desmoid tumors. https://www.doi.org/10.1055/s-0043-1767709
Developed by EPG Health for Medthority, independently of any sponsor.
DGHO 2025: Desmoid tumor updates
Watch expert insights on updates in desmoid tumor care, from Deutsche Gesellschaft für Hämatologie und Medizinische Onkologie (DGHO) 2025.
Related news and insights
of interest
are looking at
saved
next event


